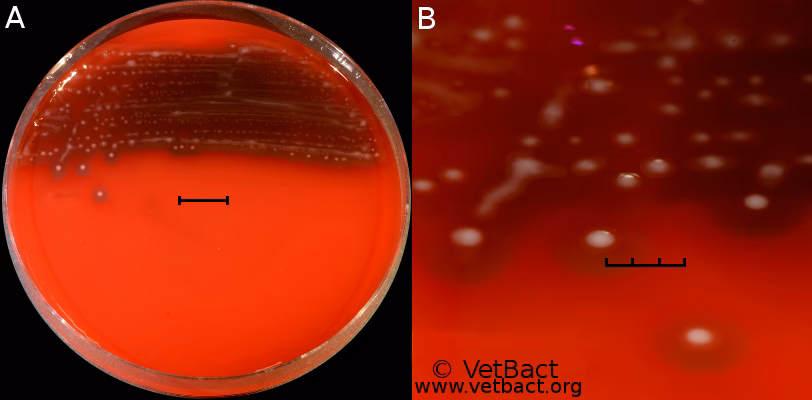

22/03/2016
Hestens paranasale bihuler er et komplekst system af luftfyldte hulrum i kraniet, der spiller en vigtig rolle for luftvejsfunktionen. Desværre er disse bihuler også modtagelige for en række lidelser, herunder infektioner, cyster og andre pladskrævende processer. En af de mest almindelige årsager til bihuleproblemer er bakteriel infektion, ofte med Streptococcus zooepidemicus som en central aktør. At forstå årsagerne, symptomerne og de moderne behandlingsmuligheder er afgørende for enhver hesteejer, der står over for en hest med ensidigt næseflåd.

Primær versus Sekundær Bihulebetændelse
Sygdomme i hestens bihuler kan groft opdeles i to hovedkategorier: primær og sekundær bihulebetændelse. Selvom symptomerne kan ligne hinanden, er årsagerne og behandlingsstrategierne vidt forskellige. Det er afgørende at identificere den underliggende årsag for at kunne iværksætte en effektiv og varig behandling.
Primær Bihulebetændelse: En Direkte Infektion
Primær bihulebetændelse opstår, når bihulerne bliver direkte inficeret, typisk i forlængelse af en mere generel øvre luftvejsinfektion, som f.eks. en forkølelse. Bakterier får adgang til bihulerne, hvor de formerer sig og skaber en betændelsestilstand. De mest almindelige bakterier, der isoleres i disse tilfælde, tilhører streptokokfamilien, især Streptococcus equi subsp. zooepidemicus. Denne bakterie er en del af den normale bakterieflora i hestens luftveje, men kan under visse omstændigheder, som f.eks. et svækket immunforsvar efter en virusinfektion, blive patogen og forårsage sygdom.
Symptomerne på primær bihulebetændelse er ofte et klart, gulligt eller grønligt næseflåd, som regel kun fra det ene næsebor. Hesten kan virke nedstemt og have let feber. Hvis infektionen opdages og behandles hurtigt med passende antibiotika og antiinflammatorisk medicin, er prognosen god. I nogle tilfælde kan det være nødvendigt at skylle bihulerne (bihulelavage) for at fjerne det ophobede pus og hjælpe med at rydde infektionen. Hvis tilstanden bliver kronisk, kan slimen blive tyk og indkapslet, hvilket gør det svært at behandle medicinsk og kan kræve et kirurgisk indgreb for at rydde bihulerne og genoprette normal drænage.
Sekundær Bihulebetændelse: Et Problem med Rod et Andet Sted
Sekundær bihulebetændelse er den mest almindelige form og opstår, når en anden lidelse skaber grobund for infektion i bihulerne. Langt den hyppigste årsag er tandproblemer. Infektion ved roden af en kindtand i overmunden (en apikal infektion) kan bryde igennem den tynde knoglevæg, der adskiller tandrødderne fra bihulerne, og dermed sprede infektionen direkte ind i bihulesystemet.
Heste med tandrelateret bihulebetændelse har ofte en lang historie med ensidigt næseflåd, der måske kortvarigt forbedres på antibiotika, men hurtigt vender tilbage. Et klassisk tegn, selvom det ikke er unikt for denne lidelse, er et ildelugtende næseflåd. Lugten skyldes vævsdød og tilstedeværelsen af anaerobe bakterier. Andre tandproblemer som diastemer (mellemrum mellem tænderne), tandfrakturer eller overflødige tænder kan også føre til sekundær bihulebetændelse. Behandlingen afhænger fuldstændigt af at identificere og fjerne den primære årsag, hvilket i de fleste tilfælde betyder tandekstraktion af den problematiske tand.
Diagnostik: Kunsten at Stille den Rigtige Diagnose
En korrekt diagnose er altafgørende for en succesfuld behandling. Dyrlægen har flere værktøjer til rådighed for at undersøge hestens bihuler.
- Endoskopi (Kikkertundersøgelse): En dyrlæge kan føre et endoskop op i hestens næse for at se, hvorfra næseflådet stammer. Dette kan bekræfte, at problemet kommer fra bihulerne, men kan sjældent skelne mellem primær og sekundær bihulebetændelse.
- Røntgen: Røntgenbilleder af hestens kranie kan vise væskeansamlinger (væskespejl) i bihulerne og kan give hints om tandrodsproblemer, såsom slørede tandrødder eller tegn på knoglebetændelse. Røntgen er dog ofte utilstrækkeligt til at stille en endelig diagnose, især ved komplekse tandproblemer.
- CT-scanning: Den absolutte guldstandard for diagnostik af bihulesygdomme er CT-scanning. En CT-scanner tager en række tværsnitsbilleder og skaber en detaljeret 3D-model af hestens hoved. Dette giver en uovertruffen visualisering af både tænder, tandrødder og bihuler. Med en CT-scanning kan dyrlægen præcist identificere den syge tand, vurdere omfanget af infektionen og udelukke andre årsager som cyster eller tumorer. I dag kan CT-scanninger ofte udføres på den stående, bedøvede hest, hvilket eliminerer risikoen ved fuld narkose.
Sammenligning af Bihulebetændelsestyper
For at give et klart overblik er her en sammenligning mellem de to primære former for bihulebetændelse.
| Karakteristik | Primær Bihulebetændelse | Sekundær Bihulebetændelse |
|---|---|---|
| Primær Årsag | Direkte bakteriel infektion (f.eks. efter forkølelse) | Underliggende problem, oftest en inficeret tandrod |
| Typiske Bakterier | Ofte en enkelt type, f.eks. S. zooepidemicus | Ofte en blandingsinfektion, inkl. anaerobe bakterier |
| Lugt fra Næseflåd | Sjældent ildelugtende | Ofte meget ildelugtende |
| Respons på Antibiotika | Godt respons og helbredelse | Midlertidig bedring, men tilbagefald når behandlingen stopper |
| Definitiv Behandling | Antibiotika, antiinflammatorisk, evt. bihuleskylning | Fjernelse af den underliggende årsag (f.eks. tandekstraktion) |
Andre Mindre Almindelige Årsager til Bihuleproblemer
Selvom infektioner er de mest almindelige, kan andre tilstande også påvirke hestens bihuler.
- Bihulecyster: Dette er væskefyldte, ekspansive blærer, der langsomt vokser og kan forårsage deformiteter i ansigtsskelettet og blokere for normal drænage, hvilket kan føre til sekundær infektion. Behandlingen er kirurgisk fjernelse af cysten.
- Progressivt Ethmoidalt Hæmatom (PEH): En ikke-kræftrelateret, men lokalt destruktiv masse, der udgår fra et bestemt område i bihulesystemet (ethmoidale labyrint). Det klassiske symptom er tilbagevendende, sparsom næseblod. Behandlingen kan involvere laser-fjernelse eller injektioner med formalin direkte i massen.
- Traumer: Et spark eller et sammenstød kan forårsage brud på knoglerne i ansigtet, hvilket kan føre til blødning og efterfølgende infektion i bihulerne.
- Neoplasi (Tumorer): Selvom det er sjældent, kan tumorer som pladecellekarcinom opstå i bihulerne. Symptomerne er ofte uspecifikke og ligner andre bihulesygdomme, hvilket kan forsinke diagnosen. Prognosen er desværre ofte dårlig.
Ofte Stillede Spørgsmål (FAQ)
Hvad er det første tegn på bihulebetændelse hos en hest?
Det mest almindelige første tegn er næseflåd fra kun det ene næsebor. Flåddet kan variere i farve og konsistens fra klart til tykt og gulligt/grønligt.
Er bihulebetændelse smitsomt for andre heste?
Den underliggende årsag kan være smitsom. Hvis en hest får primær bihulebetændelse efter en virusinfektion, kan selve virussen smitte. Bakterien S. zooepidemicus kan også overføres, men forårsager typisk kun sygdom hos heste med et svækket forsvar. Sekundær bihulebetændelse forårsaget af en dårlig tand er ikke smitsom.
Hvorfor lugter næseflådet så slemt ved tandrelateret bihulebetændelse?
Den dårlige lugt stammer fra vævsnedbrydning (nekrose) omkring den inficerede tandrod og tilstedeværelsen af specifikke bakterier (anaerobe), der trives i iltfattige miljøer og producerer ildelugtende svovlforbindelser.
Er kirurgi altid nødvendigt?
Nej, slet ikke. Akutte, primære tilfælde af bihulebetændelse kan ofte klares med medicinsk behandling alene eller i kombination med bihuleskylning. Kirurgi er forbeholdt kroniske tilfælde, hvor slimen er blevet indkapslet, eller ved sekundære årsager som tandproblemer eller cyster, der kræver fjernelse.
Afslutningsvis er det vigtigt at understrege, at ensidigt næseflåd hos en hest altid bør tages alvorligt. En hurtig og præcis diagnose fra en dyrlæge er nøglen til en vellykket behandling og kan forhindre, at en simpel infektion udvikler sig til en kronisk og kompliceret lidelse. Med moderne diagnostiske værktøjer som CT-scanning kan selv komplekse sager diagnosticeres præcist, hvilket baner vejen for målrettet og effektiv behandling, så hesten igen kan trække vejret frit.
Hvis du vil læse andre artikler, der ligner Bihulebetændelse hos heste: Årsager og behandling, kan du besøge kategorien Sundhed.